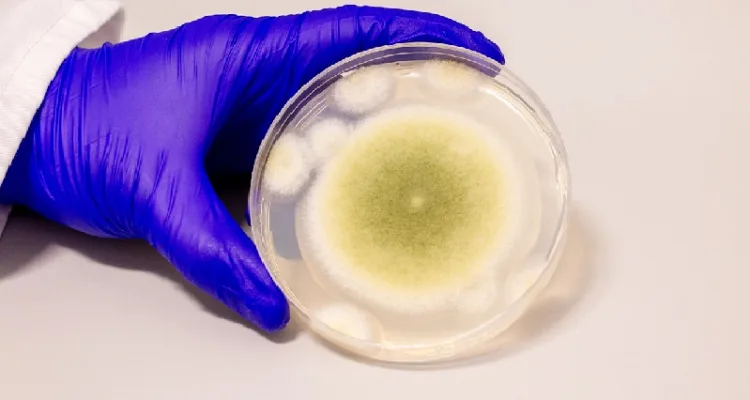

വിഷമുള്ള ഫംഗസിൽ നിന്ന് കാൻസറിനെ തോൽപ്പിക്കാൻ കഴിയുന്ന മരുന്ന് . ഏതെങ്കിലും സയന്റിഫിക്ക് ഫിക്ഷൻ സ്റ്റോറിയല്ല . യാഥാർത്ഥ്യമാണിത് . ഒരുകാലത്ത് വയലുകളിലെ വിളകൾ നശിപ്പിച്ചിരുന്ന വിഷ ഫംഗസ് ഇപ്പോൾ മനുഷ്യജീവിതങ്ങൾക്ക് പുതുജീവൻ നൽകുന്ന പ്രതീക്ഷയായി മാറിയിരിക്കുന്നു. വിഷമായി കണക്കാക്കപ്പെട്ടിരുന്ന അതേ ആസ്പർജില്ലസ് ഫ്ലാവസ് ഫംഗസ് ഇപ്പോൾ കാൻസർ ചികിത്സയിൽ ഫലപ്രദമാണെന്ന് തെളിയിക്കുന്നത് ശാസ്ത്രലോകത്ത് തന്നെ അത്ഭുതമായിരിക്കുകയാണ് . അമേരിക്കൻ ശാസ്ത്രജ്ഞരുടെ ഒരു സംഘമാണ് ഈ ഫംഗസിൽ നിന്ന് ഒരു പ്രത്യേക മൂലകം വേർതിരിച്ചെടുത്ത് മരുന്ന് തയ്യാറാക്കിയിരിക്കുന്നത് .
വിളകളിൽ കാണപ്പെടുന്ന ഒരു ഫംഗസാണ് ആസ്പർജില്ലസ് ഫ്ലാവസ്, ഇത് ‘അഫ്ലാറ്റോക്സിൻ’ എന്ന വിഷം ഉത്പാദിപ്പിക്കുന്നു. ഈ വിഷം മനുഷ്യന്റെ കരളിനും മറ്റ് അവയവങ്ങൾക്കും ഗുരുതരമായ നാശമുണ്ടാക്കും. എന്നാൽ ഇപ്പോൾ ശാസ്ത്രജ്ഞർ ഈ ഫംഗസിൽ നിന്ന് കാൻസർ കോശങ്ങളെ നശിപ്പിക്കാൻ കഴിവുള്ള ഒരു രാസ മൂലകം കണ്ടെത്തി, അതും ആരോഗ്യമുള്ള കോശങ്ങൾക്ക് ദോഷം വരുത്താതെ തന്നെ.
ഇത് ട്യൂമർ കോശങ്ങളുടെ ഡിഎൻഎ മാറ്റി നശിപ്പിക്കുന്നു. ഈ പ്രക്രിയ ശരീരത്തിലെ സാധാരണ കോശങ്ങളെ ബാധിക്കുന്നില്ല, ഇത് പാർശ്വഫലങ്ങൾക്കുള്ള സാധ്യതയും കുറയ്ക്കുന്നു. ഈ മരുന്ന് നിലവിൽ പ്രീ-ക്ലിനിക്കൽ പരീക്ഷണ ഘട്ടത്തിലാണ്, പക്ഷേ പ്രാരംഭ ഫലങ്ങൾ വളരെ പ്രതീക്ഷ നൽകുന്നതാണ്.ഇതുവരെ കീമോതെറാപ്പി, റേഡിയേഷൻ, ശസ്ത്രക്രിയ എന്നിവയായിരുന്നു കാൻസർ ചികിത്സയുടെ പ്രധാന രീതികൾ.
എന്നാൽ ഇവയെല്ലാം ശരീരത്തിൽ ആഴത്തിലുള്ള സ്വാധീനം ചെലുത്തുന്നു. ഈ പുതിയ മരുന്ന് വിജയിച്ചാൽ, കാൻസർ ചികിത്സ വേദനാജനകവും കൂടുതൽ ഫലപ്രദവുമാക്കാൻ ഇതിന് കഴിയും.അടുത്ത രണ്ടോ മൂന്നോ വർഷത്തിനുള്ളിൽ ഈ മരുന്നിന്റെ ക്ലിനിക്കൽ പരീക്ഷണങ്ങൾ ആരംഭിക്കുമെന്ന് ശാസ്ത്രജ്ഞർ പറയുന്നു. ലാബ് ഗവേഷണങ്ങളിൽ കാണിച്ചതുപോലെ മനുഷ്യശരീരത്തിൽ ഈ മരുന്ന് ഫലപ്രദമാണെന്ന് തെളിഞ്ഞാൽ, കാൻസർ ചികിത്സയിൽ അത് ഒരു വിപ്ലവകരമായ മാറ്റമായിരിക്കും